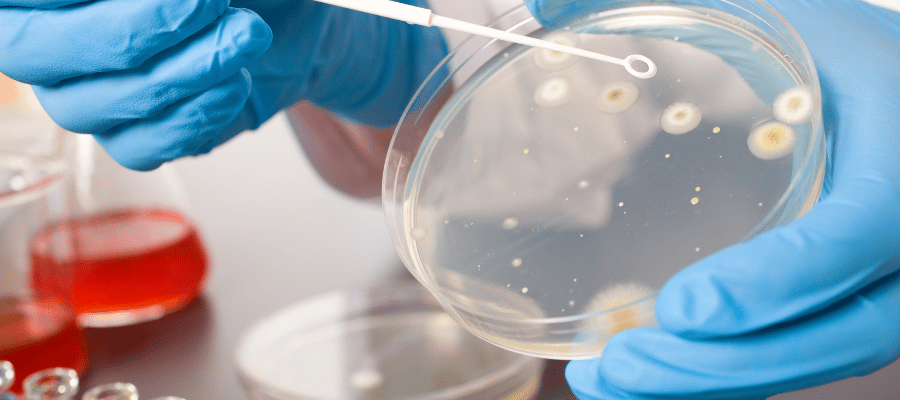
Anti HBs Seviyeleri Nasıl Artırılır?

Sağlıklı ve Uzun Yaşama İlk Adımı Atın
Anti HBs değeri, kişinin Hepatit B enfeksiyonuna veya aşıya karşı koruyucu yanıt oluşturup oluşturmadığını anlamada kullanılır. Anti HBs ölçümü özellikle bulaşıcı hastalıkların önlenmesi açısından kritik rol taşır.
Anti HBs sonuçları toplum sağlığının izlenmesi, bireysel risklerin değerlendirilmesi ve bağışıklama stratejilerinin planlanması açısından önemlidir. Anti HBs değeri düşük veya negatif olan bireylerde yeniden aşılama veya ek test gereksinimi ortaya çıkar. Anti HBs takibi modern enfeksiyon hastalıkları yaklaşımının temel parçalarından biridir.
Anti HBs Nedir?
Hepatit B yüzey antikoru olarak adlandırılan Anti HBs, vücudun Hepatit B virüsüne karşı geliştirdiği koruyucu savunma proteinidir. Hepatit B yüzey antikoru pozitifliği, virüse karşı bağışıklık geliştiğini gösterir. Anti HBs değeri genellikle Hepatit B aşısı sonrası veya geçirilmiş enfeksiyon sonrasında ortaya çıkar.
HBsAg (Hepatit B yüzey antijeni) ile birlikte değerlendirilen Anti HBs, Hepatit B paneli içinde önemli bir yer tutar. HBsAg (Hepatit B yüzey antijeni) virüsün kanda aktif olarak bulunduğunu gösterirken Anti HBs koruyucu yanıtı temsil eder. Hepatit B paneli sayesinde enfeksiyonun evresi net olarak anlaşılır.
ELISA testi yöntemi ile ölçülen Anti HBs, laboratuvarlarda yüksek doğruluk oranıyla değerlendirilir. ELISA testi bağışıklık sisteminin oluşturduğu antikorları hassas biçimde saptar. Koruyucu antikor düzeyi Anti HBs ölçümü sayesinde belirlenir.

Anti HBs Yüksekliği Neden Olur?
Anti HBs yüksekliği çoğunlukla etkili bir Hepatit B aşısı sonrası gelişen güçlü bağışıklık yanıtı ile ilişkilidir. Hepatit B aşısı bağışıklık sistemini uyararak yüksek düzeyde Hepatit B yüzey antikoru üretimini sağlar. Böylece bağışıklık durumu güçlü ve kalıcı hale gelir.
Doğal enfeksiyon sonrasında gerçekleşen serokonversiyon süreci de Anti HBs yüksekliğine yol açabilir. Serokonversiyon virüsün temizlenmesi ve antikorların ortaya çıkması anlamına gelir. HBsAg (Hepatit B yüzey antijeni) negatifleşirken Anti HBs pozitifleşir.
Aşağıdaki durumlarda Anti HBs yüksekliği görülür:
- Hepatit B aşısı sonrası yeterli bağışıklık oluşması
- Doğal enfeksiyon sonrası serokonversiyon gelişmesi
- Güçlü bağışıklık durumu varlığı
- Yeterli koruyucu antikor düzeyi sağlanması
Anti HBs Düşüklüğü Neden Olur?
Anti HBs düşüklüğü bağışıklık yanıtının zayıf olduğu anlamına gelir. Hepatit B aşısı uygulanmasına rağmen yeterli antikor üretimi gerçekleşmeyebilir. Bağışıklık durumu yaş, kronik hastalıklar veya bağışıklık baskılanması nedeniyle yetersiz kalabilir.
Bazı bireylerde ELISA testi ile ölçülen Anti HBs değeri zaman içinde azalabilir. Koruyucu antikor düzeyi uzun yıllar sonra eşik değerin altına düşebilir. Hepatit B paneli düşüşün izlenmesinde önemli rol oynar.
Anti HBs düşüklüğüne yol açabilecek durumlar şunlardır:
- Yetersiz Hepatit B aşısı yanıtı
- Bağışıklık sisteminin zayıflaması
- Uzun zaman geçmesi nedeniyle koruyucu antikor düzeyi kaybı
- Kronik hastalıkların bağışıklık durumu üzerinde olumsuz etki oluşturması
Anti HBs Seviyeleri Nasıl Artırılır?
Anti HBs seviyesinin artırılması için en etkili yöntem Hepatit B aşısı uygulamasıdır. Hepatit B aşısı tekrar dozları antikor üretimini güçlendirebilir. Bağışıklık durumu böylece desteklenir.
Düzenli takip edilen Hepatit B paneli ile Anti HBs yanıtı izlenebilir. ELISA testi ile yapılan ölçümler doğru zamanlama ile değerlendirilir. Koruyucu antikor düzeyi hedeflenen seviyeye ulaştığında yeniden enfeksiyon riski azalır.
Anti HBs artışı için önerilen yaklaşımlar şunlardır:
- Tekrar Hepatit B aşısı uygulanması
- Hepatit B paneli ile düzenli kontrol
- ELISA testi ile antikor yanıtının doğrulanması
- Güçlü bağışıklık durumu oluşturacak genel sağlık önlemleri

Anti-HBs Seviyeleri Longevity (Uzun ve Sağlıklı Yaşam) Açısından Ne Anlama Gelir?
Longevity, biyolojik yaşın optimize edilmesini merkeze alarak bireyin daha sağlıklı, enerjik ve hastalıklardan korunmuş bir yaşam sürmesini amaçlayan kişiselleştirilmiş ve bütüncül bir tıp yaklaşımıdır. Yaklaşım, sadece yaşam süresini uzatmak değil, uzun yaşanan yılların kaliteli ve sağlıklı olmasını amaçlar. Longevity planları; genetik faktörlerden yaşam tarzına, beslenmeden fiziksel aktiviteye kadar geniş bir yelpazedeki sağlık etmenlerini değerlendirir.
Anti-HBs (Hepatit B yüzey antikoru) seviyeleri, Hepatit B’ye karşı bağışıklığın göstergesidir ve yeterli seviyelerde olması, kronik karaciğer hasarı riskini azaltarak uzun ve sağlıklı yaşam şansını artırır. Kronik viral enfeksiyonlar bağışıklık sistemini zorlayarak inflamasyon ve hastalık riskini yükseltebilir; bundan dolayı sağlıklı bir bağışıklık yanıtı longevity hedefleri açısından önemlidir. Ayrıca anti-HBs düzeylerinin yeterli olması, yaşam kalitesini korumaya ve karaciğerle ilgili uzun vadeli komplikasyonları önlemeye yardımcı olur.
Bağışıklık sistemi sağlığı, yaşlanma sürecinde kronik hastalıklara yakalanma riskini azaltarak sağlıklı yaşama süresini uzatmada etkili bir rol oynar. Anti-HBs gibi korunma göstergeleri, vücudun enfeksiyonlara karşı etkin savunma mekanizmaları oluşturduğunu gösterir ve uzun dönemli sistemik inflamasyonu azaltarak longevity potansiyelini artırabilir. Genel sağlık değerlendirmelerinde bağışıklık parametrelerinin değerlendirilmesi, bütüncül tıp yaklaşımlarında önemli bir yer tutar.
Anti HBs Hakkında Sıkça Sorulan Sorular
Anti HBs değerinin kaç olması koruyucu kabul edilir?
Koruyucu antikor düzeyi genellikle 10 mIU/mL ve üzeri olarak kabul edilir. ELISA testi ile ölçülen değerler klinik olarak yorumlanır. Hepatit B yüzey antikoru 10 mIU/mL ve üzeri seviyede olduğunda koruyuculuk sağlanır.
Anti HBs pozitifliği her zaman ömür boyu bağışıklık sağlar mı?
Anti HBs düzeyi zamanla düşebilir. Bağışıklık durumu bireysel faktörlere bağlı olarak değişir. Hepatit B paneli ile takip edilmesi önerilir.
Anti HBs testi için aç karnına kan vermek gerekir mi?
ELISA testi için açlık gerekliliği bulunmaz. Hepatit B paneli her saat alınan kan örnekleri ile yapılabilir. Anti HBs ölçümü beslenmeden etkilenmez.
Aşı olmama rağmen Anti HBs neden negatif çıkıyor?
Hepatit B aşısı her bireyde yeterli antikor oluşturmayabilir. Bağışıklık durumu zayıf olan kişilerde yanıt düşük kalabilir. Koruyucu antikor düzeyi ek dozlarla artırılabilir.
Anti HBs ve HBsAg testlerinin ikisinin de pozitif olması ne anlama gelir?
HBsAg (Hepatit B yüzey antijeni) pozitifliği aktif enfeksiyonu gösterir. Anti HBs pozitifliği bağışıklık yanıtını ifade eder. Hepatit B paneli ile klinik yorum yapılır.
Anti HBs değeri zamanla düşer mi?
Anti HBs yıllar içinde azalabilir. Bağışıklık durumu yaş ve hastalıklara bağlı olarak değişebilir. Koruyucu antikor düzeyi takip edilmelidir.
Bebeklerde Anti HBs takibi nasıl yapılır?
Hepatit B aşısı sonrası Anti HBs ölçümü yapılır. ELISA testi bebeklerde de güvenle uygulanır. Hepatit B paneli ile bağışıklık doğrulanır.
Anti HBs yüksekliği bulaşıcı bir duruma işaret eder mi?
Anti HBs yüksekliği bağışıklık göstergesidir. HBsAg (Hepatit B yüzey antijeni) negatifliği bulaşıcılığın olmadığını gösterir. Hepatit B yüzey antikoru koruyucu rol oynar.
Hepatit B geçiren birinde Anti HBs ne zaman oluşur?
Serokonversiyon sürecinden sonra Anti HBs ortaya çıkar. HBsAg (Hepatit B yüzey antijeni) kaybolduğunda antikor gelişimi başlar. Bağışıklık durumu güçlenir.
Anti HBs seviyesi düşük olanlar tekrar aşılanmalı mıdır?
Koruyucu antikor düzeyi düşük bireylerde tekrar Hepatit B aşısı önerilir. ELISA testi ile yanıt izlenir. Bağışıklık durumu yeniden güçlendirilebilir.
Hamilelikte Anti HBs testi yapılması zorunlu mudur?
Hepatit B paneli gebelikte önerilen testler arasında yer alır. Anti HBs varlığı bebeğin korunması açısından önemlidir. HBsAg (Hepatit B yüzey antijeni) de mutlaka değerlendirilir.
Anti HBs sonucunun reaktif veya non-reaktif olması ne demektir?
Anti HBs reaktif sonucu pozitif antikor varlığını gösterir. Non-reaktif sonucu koruyucu yanıt bulunmadığını ifade eder. Koruyucu antikor düzeyi reaktif durumda yeterli kabul edilir.
Bu içerik kayıt tarihindeki bilimsel verilerle hazırlanmış olup Acıbadem Life Sağlık Hizmetleri Medikal Direktörlüğü tarafından kontrol edilmiştir.